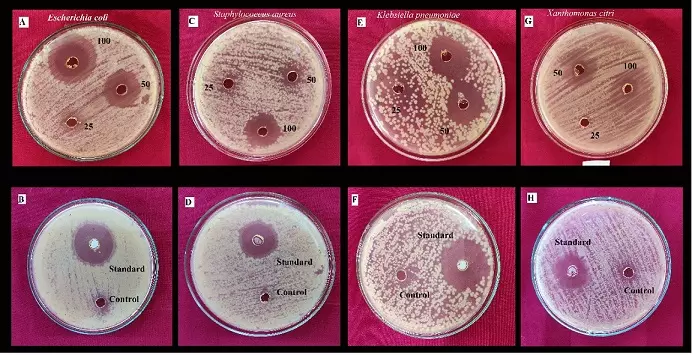
Graphical Abstract

Comparative and Bioinformatics Analyses of the Solanaceae Chloroplast Genomes: Plastome Organization is more or Less Conserved at Family Level
Dipen Ghimiray and Binod Chandra Sharma
DOI: 10.7324/JABB.2014.2305Pages: 021-026

Analysis of genetic population structure of an endangered Serranid fish species in the South Korean waters: a bioinformatic simulation
Khaled Mohammed-Geba
DOI: 10.7324/JABB.2015.3105Pages: 024-029

Report of the incidence of a new rare strain of Cladosporium species and incidence of three other Cladosporium species in the intramural environment of Bengaluru, India
Jyoti Bharamgoud Marigoudar, Narendra Kuppan
DOI: 10.7324/JABB.2022.100211Pages: 89-95

Molecular characterization and antibacterial properties of endophytic fungi Lasidiplodia theobromae in Lobelia nicotianifolia Roth ex Schult. of central Western Ghats of Karnataka, India
Krishnappa Vinu, Maddappa Krishnappa, Venkatarangaiah Krishna
DOI: 10.7324/JABB.2022.100411Pages: 77-85